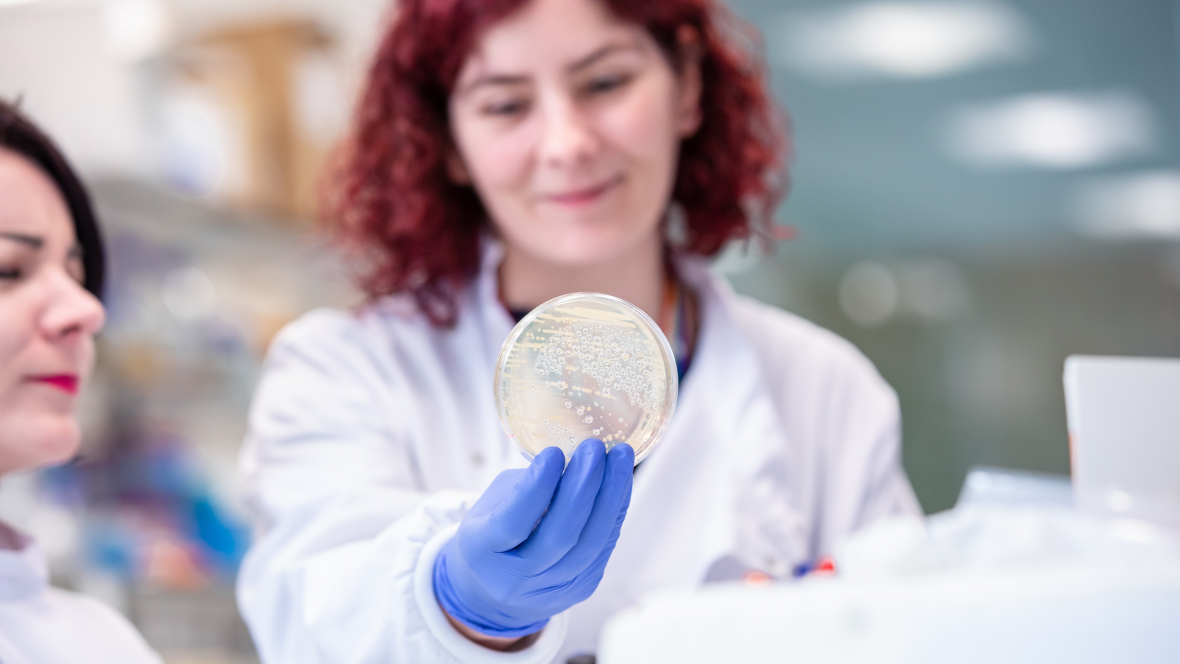

Northern Ireland on the world stage - did you know?
Lord Kelvin, the father of modern science, was born in Belfast in 1824.
The portable defibrillator was designed in Northern Ireland in the 1960s by Professor Frank Pantridge.
The process emergency departments use to treat cardiac arrest is known as 'The Belfast Protocol'.
Each year, more than 370 million people receive medical diagnosis using Randox products.
Northern Ireland has a unique Life and Health Sciences ecosystem.
Much of the local industry’s success is attributed to the region’s universities, companies, regulatory authorities, and healthcare systems being connected in a way that fosters great collaboration. It’s the type of integration that simply does not occur in larger countries or regions of a similar size.
The companies operating in Northern Ireland can support all aspects of the development cycle, from discovery through preclinical and clinical research, to commercial manufacturing and lifecycle management.
Companies operating here have direct access to the UK’s National Health Service (NHS) as well as Northern Ireland’s data-driven closed-loop healthcare system, which has full longitudinal electronic health records for the population of 1.9 million, covering from birth through old age. Data of this scope does not exist in many places and offers opportunities for comparative efficacy research and data mining. Through ethical collaboration agreements, researchers can access this information to find ideal patient pools – even for more complicated diseases – creating an ideal environment for the co-creation, testing, evidence generation, and adoption of healthcare innovations.
Today, over 250 Life and Health Sciences companies operate in Northern Ireland, including global names like Randox, Almac, Norbrook, G&L Scientific, and Teva Pharmaceutical Industries.
Together, Northern Ireland companies and investors of all sizes are focused on advancing medical devices, pharma, diagnostics, precision medicine, and connected health.
Northern Ireland has globally competitive research expertise.
Ulster University and Queen’s University Belfast, Northern Ireland’s two major universities, provide globally competitive research expertise, including 17 life sciences-related research centres and a proven track record in commercialising healthcare technologies.
Ulster University’s Connected Health Innovation Centre (CHIC) is a leader in connected health research, with a focus on the management of long-term chronic conditions. They are making significant advancements in the areas of sensors, from those that monitor a patient’s health status and identify early signs of illness to those that track electrical responses in the brains of patients with neurodegenerative diseases, providing real-time feedback during clinical studies.
Working closely with the universities is the Health Innovation Research Alliance Northern Ireland (HIRANI). HIRANI is an alliance of universities, health organisations, and other industry bodies, established to drive and support ambitious growth in the sector. HIRANI acts as a “shop window” for Northern Ireland’s Life and Health Sciences sector, offering partners and investors easy access to industry resources and expertise.
Northern Ireland Life and Health Sciences sector has strong government support.
The Northern Ireland government proactively supports the Life and Health Sciences sector. As the region’s economic development agency, Invest Northern Ireland helps companies looking to establish operations in the region by brokering collaborations with local business, academia, and health organisations; providing research and entrepreneurship funding; and advising how best to scale. Essentially, the organisation serves as a catalyst helping companies identify and connect with the locations, people, and resources that will ensure their success.
When companies consider talent, cost, regulatory compliance, product quality and availability, IP protection, and now unique dual-market access, Northern Ireland is poised to play an essential and ever-growing role.
Browse Companies
32
 Let's connect
Let's connect
 Let's connect
Let's connect
 Let's connect
Let's connect
 Let's connect
Let's connect
 Let's connect
Let's connect
 Let's connect
Let's connect
 Let's connect
Let's connect
 Let's connect
Let's connect
 Let's connect
Let's connect
 Let's connect
Let's connect
 Let's connect
Let's connect
 Let's connect
Let's connect
 Let's connect
Let's connect
 Let's connect
Let's connect
 Let's connect
Let's connect
 Let's connect
Let's connect
 Let's connect
Let's connect
 Let's connect
Let's connect
 Let's connect
Let's connect
 Let's connect
Let's connect
 Let's connect
Let's connect
 Let's connect
Let's connect
 Let's connect
Let's connect
 Let's connect
Let's connect
 Let's connect
Let's connect
 Let's connect
Let's connect
 Let's connect
Let's connect
 Let's connect
Let's connect
 Let's connect
Let's connect
 Let's connect
Let's connect
 Let's connect
Let's connect
 Let's connect
Let's connect